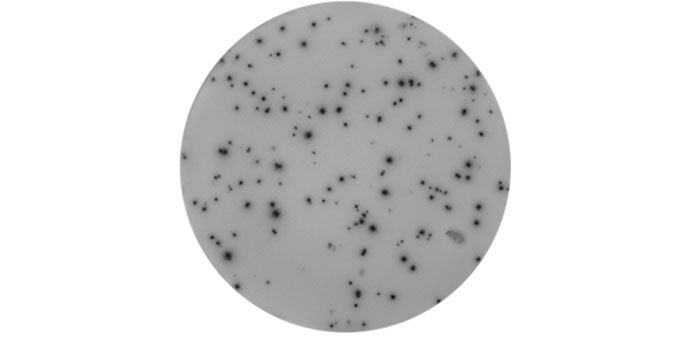

T-cell ELISpot Proficiency Testing
Originally developed at the initiative of CIC (the US Cancer Immuno-therapy Consortium of the CRI) and CIMT (the European Association for Cancer Immunotherapy), Immudex offers Proficiency Testing as a non-profit service to help researchers and clinicians worldwide evaluate and benchmark their immune monitoring performance with T-cell ELISpot assays.
Using laboratory-specific protocols, plates, and plate reader, participants determine the number of IFN-γ secreting antigen-specific T cells in provided PBMC samples using ELISpot and receive a report comparing the results from all participating laboratories.
What You Receive
PBMC samples: identical for all participants
Peptide pools: PepMix™ HCMV (pp65) + CEFX Ultra SuperStim Pool
Negative control reagent
Assay instructions
What You Measure
Spot count per well after stimulation with either a peptide pool or a negative control reagent
T-cell ELISpot Proficiency Testing Service – step-by-step
|
Registration opens February 2023 |
||||
SIGN UP |
RECEIVE SAMPLES |
ANALYZE SAMPLES |
UPLOAD DATA |
RECEIVE REPORT |
 |
 |
 |
 |
 |
|
Register |
PBMC JPT’s PepMixTM HCMVA (pp65), CEFX Ultra SuperStim Pool and a negative control reagent Assay instructions |
Use your own protocol to analyze PBMC samples according to the instructions | Report your results back to Immudex | Get a report with all participants' performance |

Proficiency Performance 2021
In the ELISpot Proficiency Panel 2021, all laboratories received identical PBMC samples for identification of IFN-γ secreting antigen-specific T-cells, and results were collated to assess the relative accuracy of results across the different laboratories. 13 of the 29 participants (44,8%) had a relative accuracy of between 0.66-1.5 and are considered to be “in the average range” (dark purple columns).
Learn more in the T-cell ELISpot Proficiency Panels 2021
Performance Reports
T-cell ELISpot Proficiency Panels 2023 Group 2
T-cell ELISpot Proficiency Panels 2023 Group 1
T-cell ELISpot Proficiency Panels 2021
T-cell ELISpot Proficiency Panels 2020
T-cell ELISpot Proficiency Panels 2019
T-cell ELISpot Proficiency Panels 2017
Acknowledgements
JPT Peptide Technologies sponsors peptide pools used in the ELISpot assays.
Mabtech conducts quality control of the PBMC samples before these are shipped to participants.
